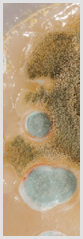

ALLPHASE COMPANIES, INC

-
- Landfills
-
- Asbestos
-
- Lead
-
- Mold Evaluation
-
- Tank Removal
-
- Site Assessments
-
- Oil Spills
AllPhase Companies Inc. is a full service, environmental consulting firm specializing in
Environmental
We have a long and successful history of making this world a better place through our attention to detail, the process we follow in our preparation, implementation, and execution, and our knowledge and understanding of the ever-changing rules and regulations.
Contact us about any of your environmental issues or concerns and we will be glad to assist you. We can save you money by combining evaluation, removal, and restoration. AllPhase Companies is a one-stop shop for all your environmental needs as we also have a construction branch of the company so we can restore your site. We specialize in commercial building and demolition. AllPhase Companies will provide you with an honest knowledgeable, efficient and cost effective solution.
-
- Emergency Clean Up
-
- Environmental Impact Assessments
-
- Phase I, II, and III Assessments
-
- Clean-Ups of All Types

-
- RCRA Sites
-
- CERCLA Sites
-
- NPL Sites
-
- The Environmental Impact Association (EIA)
-
- Petro Funding, PECFA
-
- Super Funding Sites
-
- Minnesota Priority Pollutant Sites (PLP’s)
We work with: